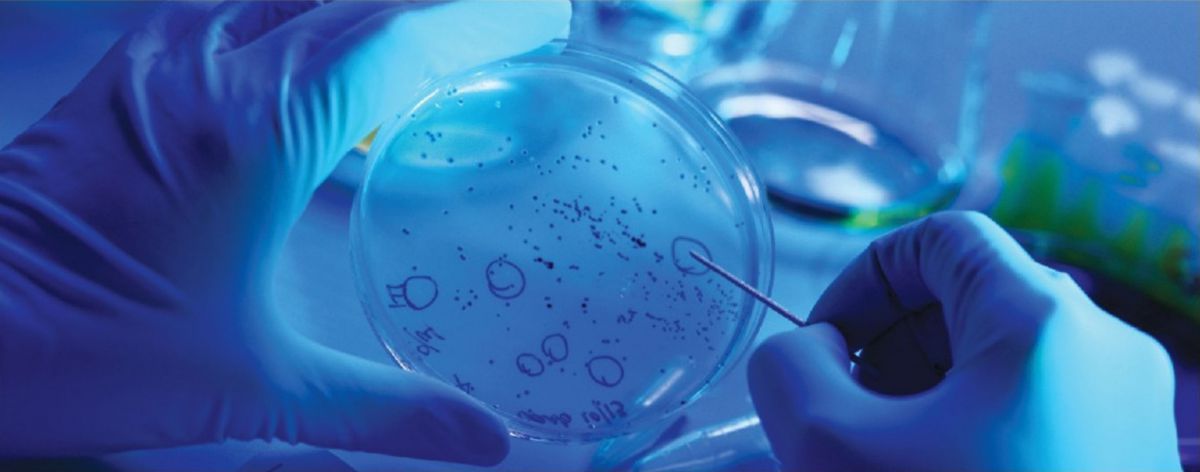

Nhà máy đạt chuẩn GMP
Giấy phép số: 2009-Daegu-0003 / Số: 20174-9161 Diện tích: 9.900m²/ Địa chỉ: Số 856-11, đường Sinjae-ro, thị
trấn Punggi, thành phố Yeongju, tỉnh Gyeongsangbuk-do
Nhà máy GMP của Hợp tác xã nhân sâm Punggi – đơn vị chuyên sản xuất hồng sâm chất lượng cao – đã được chứng nhận là cơ sở áp dụng GMP từ tháng 8 năm 2009 nhằm đảm bảo chất lượng và an toàn cho thực phẩm chức năng. Từ khâu sản xuất, chế biến đến phân phối, nhà máy áp dụng hệ thống quản lý truy xuất nguồn gốc thực phẩm, ghi chép và kiểm soát toàn bộ thông tin theo từng giai đoạn. Nhờ đó, khi có vấn đề phát sinh liên quan đến sản phẩm, có thể nhanh chóng truy vết, xác định nguyên nhân và thực hiện các biện pháp xử lý cần thiết.

Chứng nhận GMP
GMP là viết tắt của “Good Manufacturing Practice” (Tiêu chuẩn thực hành sản xuất tốt cho thực phẩm chức năng). Đây là tiêu chuẩn quy định các điều kiện cần thiết để sản xuất thực phẩm chức năng có chất lượng cao. GMP là một hệ thống cho phép các cơ sở sản xuất thực phẩm chức năng thiết lập quy trình sản xuất đảm bảo sản phẩm luôn đạt chất lượng theo tiêu chuẩn nhất định, thông qua việc quản lý công đoạn sản xuất và vệ sinh một cách chuẩn hóa

1
Phân tích mối nguy
Xác định các mối nguy sinh học, hóa học và vật lý có thể phát sinh từ nguyên, phụ liệu hoặc trong quá trình sản xuất.
2
Xác định điểm kiểm soát tới hạn
Xác định và thiết lập các công đoạn then chốt trong quy trình có thể kiểm soát hoặc loại bỏ mối nguy đã nhận diện.
3
Thiết lập giới hạn tới hạn cho từng điểm kiểm soát quan trọng
Đưa ra các điều kiện xử lý cụ thể để đảm bảo mối nguy bị loại bỏ hoặc kiểm soát tại điểm kiểm soát.
4
Thiết lập hệ thống giám sát tại các điểm kiểm soát quan trọng
Đưa ra phương pháp theo dõi, kiểm tra và ghi chép để đảm bảo điều kiện xử lý luôn nằm trong giới hạn an toàn đã thiết lập.
5
Xây dựng biện pháp khắc phục
Khi phát hiện điều kiện xử lý vượt quá giới hạn cho phép, phải có phương án khắc phục kịp thời để đảm bảo an toàn thực phẩm.
6
Xây dựng thủ tục kiểm tra và xác minh
Xác minh xem các điểm kiểm soát và giới hạn đưa ra có phù hợp không, hoạt động giám sát có hiệu quả không và thực hiện cải tiến nếu cần thiết.
7
Thiết lập hệ thống lưu trữ tài liệu và hồ sơ
Ghi chép đầy đủ toàn bộ quá trình từ phân tích mối nguy, thiết lập điểm kiểm soát, đến xác minh – nhằm đảm bảo truy xuất và minh bạch thông tin khi cần.